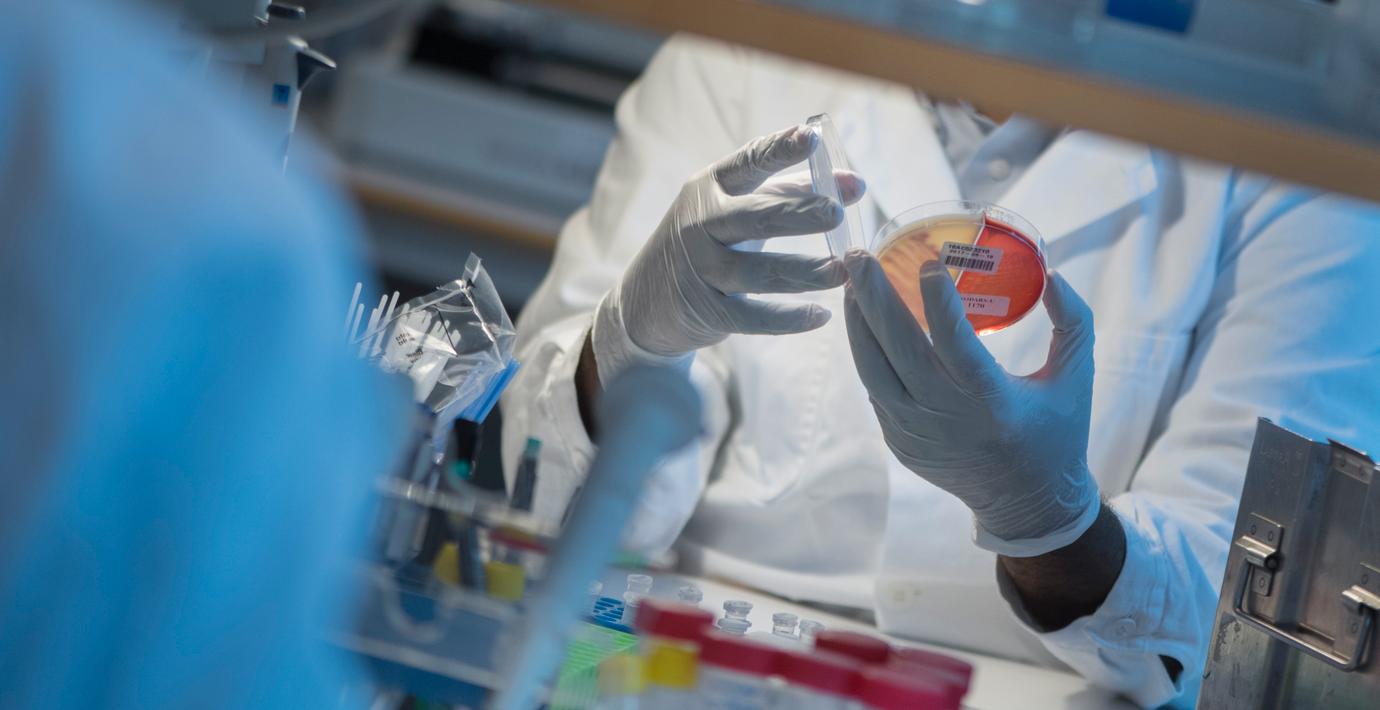

Cancerforskning i Sverige halkar efter
Sverige har halkat efter andra länder i flera avseenden inom cancerforskningen. Det rapporterar SvD och TT med hänvisning till en ny rapport från Cancerfonden. Bland annat har Sverige ramlat till 14:e plats – från åttonde plats som bästa placering – i statistiken över antalet publicerade vetenskapliga artiklar i ansedda medicinska tidskrifter.
– Många länder satsar väldigt mycket mer på att skapa ett bra forskarklimat medan vi tappar i både kvantitet och kvalitet, säger Klas Kärre, ordförande i fondens forskningsnämnd, till tidningen.
Omni är politiskt obundna och oberoende. Vi strävar efter att ge fler perspektiv på nyheterna. Har du frågor eller synpunkter kring vår rapportering? Kontakta redaktionen



